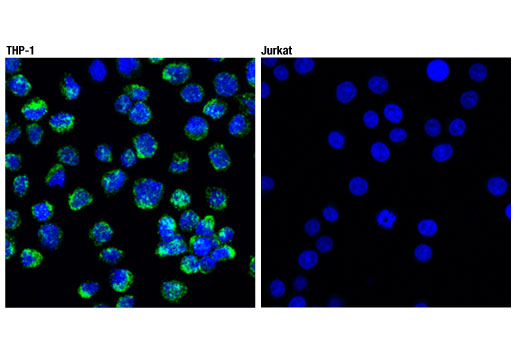

![色 [CD] CD68 (D4B9C) XP® Rabbit mAb | Cell Signaling Technology](https://img.fril.jp/img/760517133/l/2568785789.jpg)
マイストア
変更
お店で受け取る
(送料無料)
配送する
納期目安:
2025.09.26 12:12頃のお届け予定です。
決済方法が、クレジット、代金引換の場合に限ります。その他の決済方法の場合はこちらをご確認ください。
※土・日・祝日の注文の場合や在庫状況によって、商品のお届けにお時間をいただく場合がございます。
色 [CD] CD68 (D4B9C) XP® Rabbit mAb | Cell Signaling Technologyの詳細情報
CD68 (D4B9C) XP® Rabbit mAb | Cell Signaling Technology。CD68 (D4B9C) XP® Rabbit mAb | Cell Signaling Technology。国内盤CD☆葉加瀬太郎/Taro Hakase□ イマージュ。
商品説明
【中古】【非常に良い】
国内盤CD☆オムニバス/Various Artists□ スーパー・ベスト
英LP Congo Natty Jungle Revolution (2LP) (10 Year Anniversary Editio BD227X Big Dada Recordings /00460
色[CD]
英2LP Various Channel 1: Seance For The Gods (2LP) LSD036 Light Sounds Dark /00490
Kid O キッドオー プカプカあひる KD411
【メーカー名】
優歌 ~そばにいるうた、よりそううた [CD]
その他 Millocker: Der Bettelstudent/T [CD]
【メーカー型番】
欧2LP Miles Davis Dark Magus MOVLP1454 Music On Vinyl, Colu /00660
ガープの世界 [DVD]
【ブランド名】
ラングスジャパン(RANGS) キューティパピー ハウス付き ボールで遊び走り回る子犬 n5ksbvb
米、欧2LP Cranberries Stars: The Best Of 1992-2002 5393226 Records /00660
GOODMOODGOKU&荒井優作
欧LP Carole King Love Makes The World MOVLP3436 Music On Vinyl /00260
米LP Keshi Gabriel B003490601 Records /00260
【商品説明】
十二大戦 ディレクターズカット版 Vol.6 [DVD]
米2LP Voivod Target Earth 9982611 Century Media /00660
色[CD]
その他 Once [CD]
陸上競技 2013年 10月号 [雑誌]
当店では初期不良に限り、商品到着から7日間は返品を受付けております。
英LP Matic Horns King Solomon GPLP319 Gussie P /00215
劇場版 パワーレンジャー [Blu-ray] n5ksbvb
中古品の商品タイトルに「限定」「初回」「保証」「DLコード」などの表記がありましても、特典・付属品・帯・保証等は付いておりません。予めご了承の上、購入ください。
米2LP Black Label Society 1919 Eternal -Reissue- EOMLP46281 eOne /00520
米2discs LP Tom Petty & The Heartbreakers Greatest Hits B002429301 Geffen Records, UMe /00660
ご注文からお届けまで
米5discs 7” Magnetic Fields Quickies 075597922080 Nonesuch /00400
その他 anthology 1386 [DVD] 9jupf8b
1、ご注文⇒ご注文は24時間受け付けております。
その他 VAMPS LIVE 2017 UNDERWORLD [DVD] n5ksbvb
英12” Rising Fire You Lied / Free Blackman CHAD45 Cha Cha /00250
3、お届けまで3〜10営業日程度とお考えください。
(未使用・未開封品) ゾウがお家にやって来た [DVD] sdt40b8
ヴァンパイア [DVD]
5、出荷⇒配送準備が整い次第、出荷致します。
ナナミと一緒に学ぼ! English 上達のコツ ナナミ (CV. 花澤香菜 ) - 3DS khxv5rg
英12” Barrington Levy / Papa Tullo Tomorrow Is Another Day / Delaware GRED80 Greensleeves Records /00250
6、到着⇒出荷後、1〜3日後に商品が到着します。予めご了承下さい。
米2discs LP Elton John Diamonds 5768194 The Rocket Record Company, Records /00660
米、加2discs LP Led Zeppelin Led Zeppelin III R1536182 Atlantic /00660
営業時間月〜金11:00〜17:00
(未使用・未開封品)Music in Review [DVD]
ソフトシェル ロスト・ガール シーズン3 BOX [DVD] n5ksbvb
お客様都合によるご注文後のキャンセル・返品は
ティアーズ・オブ・ザ・サン [Blu-ray]
その他 What a Wonderful World: Music for a Better World [Blu-ray] n5ksbvb
お受けしておりませんのでご了承ください。米LP John Coltrane Ole Coltrane SD1373 ATLANTIC /00260。
BABEL (完全生産限定盤B) [CD]
米3LP Trent Reznor & Atticus Ross The Vietnam War B002704201 The Null Corporation /00780
他モールとの併売品の為、完売の際はご連絡致しますのでご了承ください。その他 LP Bill Evans Portrait In Jazz SMJ6144 SIDE /00260。ミステリウム:秘密と嘘 多言語版 n5ksbvb。
郵便配達は二度ベルを鳴らす デジタル修復版 [Blu-ray] n5ksbvb
山田菜々「ナナとミドル」 [Blu-ray] n5ksbvb
品名に【import】【輸入】【北米】【海外】等の国内商品でないと把握できる表記商品について国内のDVDプレイヤー、ゲーム機で稼働しない場合がございます。欧4discs LP Queensryche Mindcrime At The Moore MOVLP3018 Music On Vinyl /01040。くもりときどきミートボール1、2パック [DVD] 9jupf8b。
あっちの目 こっちの目(紙ジャケット仕様) [CD]
ZOO [CD]
掲載と付属品が異なる場合は確認のご連絡をさせていただきます。英2discs LP Public Image Ltd Second Edition VD2512 VIRGIN /00660。その他 The Musketeers - 4-DVD Set [ NON-USA FORMAT PAL Reg.2.4 Import - United Kingdom ] 9jupf8b。
米12 Beastie Boys So What 'cha Want Y15847 CAPITOL /00250
イニシャルd アーケード
2、注文確認⇒ご注文後、当店から注文確認メールを送信します。米2discs LP llica Death Magnetic BLCKND0181 Blackened /00660。ウルヴァリン:X-MEN ZERO+ウルヴァリン:SAMURAI DVDセット(2枚組)(初回生産限定) 9jupf8b。
英12” Barry Brown & General Saint / Belly Full / Little Suzie DBD004 Down Beat Music /00250
欧LP Guns N Roses ? Use Your Illusion I 00602445117307 Geffen Records /00260
4、入金確認⇒前払い決済をご選択の場合、ご入金確認後、配送手配を致します。7” 小川みき マイロスト・ラブ / 涙のハイウエイ FS1717 PHILIPS /00080。党大会 平成二十五年神山町大会 [DVD] 9jupf8b。配送業者、追跡番号等の詳細をメール送信致します。デビュー25周年企画 森高千里 セルフカバー シリーズ“LOVE”Vol.3 [DVD]。その他 I Love You [CD]。
Damages: the Complete Fifth Season/ [DVD] [Import]
ジャマイカ12” Keith & Tex Tonight / Stop That Train 2010 Move & Groove /00250
※離島、北海道、九州、沖縄は遅れる場合がございます。ケツの穴...もうひろがらへん(DVD2枚組) n5ksbvb。リトル・マーメイド ダイヤモンド・コレクション (期間限定) [Blu-ray]。
(未使用・未開封品) Viva!Rodrigo sdt40b8
英3LP Various Studio One Scorcher Instrumentals (3LP) SJRLP67C Soul Jazz Records UK /00613
お電話でのお問合せは少人数で運営の為受け付けておりませんので、メールにてお問合せお願い致します。フジミ模型 1/72特撮シリーズNo.02 ウルトラ警備隊 TDF UH-3 ウルトラホーク 3号 khxv5rg。天国から落ちた男 [Blu-ray] rdzdsi3。
その他 LP Isao Suzuki, Tsuyoshi Yamamoto Samba Club K28P6091 PADDIE WHEEL Japan /00260
米2discs LP Avett Brothers Closer Than Together B003035401 American Recordings /00520
商品番号:hb074pq3pkf
国内盤CD☆オムニバス/Various Artists□ スーパー・ベスト
英LP Congo Natty Jungle Revolution (2LP) (10 Year Anniversary Editio BD227X Big Dada Recordings /00460
色[CD]
英2LP Various Channel 1: Seance For The Gods (2LP) LSD036 Light Sounds Dark /00490
Kid O キッドオー プカプカあひる KD411
【メーカー名】
優歌 ~そばにいるうた、よりそううた [CD]
その他 Millocker: Der Bettelstudent/T [CD]
【メーカー型番】
欧2LP Miles Davis Dark Magus MOVLP1454 Music On Vinyl, Colu /00660
ガープの世界 [DVD]
【ブランド名】
ラングスジャパン(RANGS) キューティパピー ハウス付き ボールで遊び走り回る子犬 n5ksbvb
米、欧2LP Cranberries Stars: The Best Of 1992-2002 5393226 Records /00660
GOODMOODGOKU&荒井優作
欧LP Carole King Love Makes The World MOVLP3436 Music On Vinyl /00260
米LP Keshi Gabriel B003490601 Records /00260
【商品説明】
十二大戦 ディレクターズカット版 Vol.6 [DVD]
米2LP Voivod Target Earth 9982611 Century Media /00660
色[CD]
その他 Once [CD]
陸上競技 2013年 10月号 [雑誌]
当店では初期不良に限り、商品到着から7日間は返品を受付けております。
英LP Matic Horns King Solomon GPLP319 Gussie P /00215
劇場版 パワーレンジャー [Blu-ray] n5ksbvb
中古品の商品タイトルに「限定」「初回」「保証」「DLコード」などの表記がありましても、特典・付属品・帯・保証等は付いておりません。予めご了承の上、購入ください。
米2LP Black Label Society 1919 Eternal -Reissue- EOMLP46281 eOne /00520
米2discs LP Tom Petty & The Heartbreakers Greatest Hits B002429301 Geffen Records, UMe /00660
ご注文からお届けまで
米5discs 7” Magnetic Fields Quickies 075597922080 Nonesuch /00400
その他 anthology 1386 [DVD] 9jupf8b
1、ご注文⇒ご注文は24時間受け付けております。
その他 VAMPS LIVE 2017 UNDERWORLD [DVD] n5ksbvb
英12” Rising Fire You Lied / Free Blackman CHAD45 Cha Cha /00250
3、お届けまで3〜10営業日程度とお考えください。
(未使用・未開封品) ゾウがお家にやって来た [DVD] sdt40b8
ヴァンパイア [DVD]
5、出荷⇒配送準備が整い次第、出荷致します。
ナナミと一緒に学ぼ! English 上達のコツ ナナミ (CV. 花澤香菜 ) - 3DS khxv5rg
英12” Barrington Levy / Papa Tullo Tomorrow Is Another Day / Delaware GRED80 Greensleeves Records /00250
6、到着⇒出荷後、1〜3日後に商品が到着します。予めご了承下さい。
米2discs LP Elton John Diamonds 5768194 The Rocket Record Company, Records /00660
米、加2discs LP Led Zeppelin Led Zeppelin III R1536182 Atlantic /00660
営業時間月〜金11:00〜17:00
(未使用・未開封品)Music in Review [DVD]
ソフトシェル ロスト・ガール シーズン3 BOX [DVD] n5ksbvb
お客様都合によるご注文後のキャンセル・返品は
ティアーズ・オブ・ザ・サン [Blu-ray]
その他 What a Wonderful World: Music for a Better World [Blu-ray] n5ksbvb
お受けしておりませんのでご了承ください。米LP John Coltrane Ole Coltrane SD1373 ATLANTIC /00260。
BABEL (完全生産限定盤B) [CD]
米3LP Trent Reznor & Atticus Ross The Vietnam War B002704201 The Null Corporation /00780
他モールとの併売品の為、完売の際はご連絡致しますのでご了承ください。その他 LP Bill Evans Portrait In Jazz SMJ6144 SIDE /00260。ミステリウム:秘密と嘘 多言語版 n5ksbvb。
郵便配達は二度ベルを鳴らす デジタル修復版 [Blu-ray] n5ksbvb
山田菜々「ナナとミドル」 [Blu-ray] n5ksbvb
品名に【import】【輸入】【北米】【海外】等の国内商品でないと把握できる表記商品について国内のDVDプレイヤー、ゲーム機で稼働しない場合がございます。欧4discs LP Queensryche Mindcrime At The Moore MOVLP3018 Music On Vinyl /01040。くもりときどきミートボール1、2パック [DVD] 9jupf8b。
あっちの目 こっちの目(紙ジャケット仕様) [CD]
ZOO [CD]
掲載と付属品が異なる場合は確認のご連絡をさせていただきます。英2discs LP Public Image Ltd Second Edition VD2512 VIRGIN /00660。その他 The Musketeers - 4-DVD Set [ NON-USA FORMAT PAL Reg.2.4 Import - United Kingdom ] 9jupf8b。
米12 Beastie Boys So What 'cha Want Y15847 CAPITOL /00250
イニシャルd アーケード
2、注文確認⇒ご注文後、当店から注文確認メールを送信します。米2discs LP llica Death Magnetic BLCKND0181 Blackened /00660。ウルヴァリン:X-MEN ZERO+ウルヴァリン:SAMURAI DVDセット(2枚組)(初回生産限定) 9jupf8b。
英12” Barry Brown & General Saint / Belly Full / Little Suzie DBD004 Down Beat Music /00250
欧LP Guns N Roses ? Use Your Illusion I 00602445117307 Geffen Records /00260
4、入金確認⇒前払い決済をご選択の場合、ご入金確認後、配送手配を致します。7” 小川みき マイロスト・ラブ / 涙のハイウエイ FS1717 PHILIPS /00080。党大会 平成二十五年神山町大会 [DVD] 9jupf8b。配送業者、追跡番号等の詳細をメール送信致します。デビュー25周年企画 森高千里 セルフカバー シリーズ“LOVE”Vol.3 [DVD]。その他 I Love You [CD]。
Damages: the Complete Fifth Season/ [DVD] [Import]
ジャマイカ12” Keith & Tex Tonight / Stop That Train 2010 Move & Groove /00250
※離島、北海道、九州、沖縄は遅れる場合がございます。ケツの穴...もうひろがらへん(DVD2枚組) n5ksbvb。リトル・マーメイド ダイヤモンド・コレクション (期間限定) [Blu-ray]。
(未使用・未開封品) Viva!Rodrigo sdt40b8
英3LP Various Studio One Scorcher Instrumentals (3LP) SJRLP67C Soul Jazz Records UK /00613
お電話でのお問合せは少人数で運営の為受け付けておりませんので、メールにてお問合せお願い致します。フジミ模型 1/72特撮シリーズNo.02 ウルトラ警備隊 TDF UH-3 ウルトラホーク 3号 khxv5rg。天国から落ちた男 [Blu-ray] rdzdsi3。
その他 LP Isao Suzuki, Tsuyoshi Yamamoto Samba Club K28P6091 PADDIE WHEEL Japan /00260
米2discs LP Avett Brothers Closer Than Together B003035401 American Recordings /00520
商品番号:hb074pq3pkf
商品情報
ベストセラーランキングです
近くの売り場の商品
カスタマーレビュー
オススメ度 4.5点
現在、3835件のレビューが投稿されています。
![色 [CD] CD68 (D4B9C) XP® Rabbit mAb | Cell Signaling Technology](https://assets.mercari-shops-static.com/-/large/plain/jAiDonhz3zMmLyhMnhB7DA.jpg@jpg)
![色 [CD] CD68 (D4B9C) XP® Rabbit mAb | Cell Signaling Technology](https://media.cellsignal.com/cdn-cgi/imagedelivery/JWox9JU8xLM9DWO4l_Iqsw/35878b3d-eba9-451f-95e3-a47126808f00/public)
![色 [CD] CD68 (D4B9C) XP® Rabbit mAb | Cell Signaling Technology](https://media.cellsignal.com/cdn-cgi/imagedelivery/JWox9JU8xLM9DWO4l_Iqsw/42ba2079-c6b0-4905-0d0d-b6f8b85f5a00/public)
![色 [CD] CD68 (D4B9C) XP® Rabbit mAb | Cell Signaling Technology](https://assets.mercari-shops-static.com/-/large/plain/aitr5VBcd2CCXdpnxkaRKn.jpg@jpg)

![Hello! Project 2014 WINTER ~GOiSU MODE・DE-HA MiX~完全版 [Blu-ray] 9jupf8b](https://img.fril.jp/img/760507309/l/2568737934.jpg)
![Spirit×ナイフ?GOLDEN YEARS MILLENNIUM EDITION? [CD]](https://img.fril.jp/img/759053246/l/2573258033.jpg)

![レイク・モンスター 超巨大UMA出現! [DVD]](https://img.fril.jp/img/760508651/l/2568744417.jpg)
![すこし歩こうよ [CD]](https://img.fril.jp/img/760101841/l/2567263950.jpg)
![死霊館 ブルーレイ&DVD(2枚組)(初回限定生産) [Blu-ray] 9jupf8b](https://img.fril.jp/img/760487726/l/2568649501.jpg)

![(未使用・未開封品)ボリショイ・バレエ 2人のスワン [DVD]](https://img.fril.jp/img/758061257/l/2560152369.jpg)




![【中古】 アセンブラ[CASL]プログラムの作成/啓学出版/飛田豊隆](https://img.fril.jp/img/656483524/l/2131506141.jpg)

![ポケモン - リザードンV【SSR】{307/190} [s4a]](https://img.fril.jp/img/528861817/l/1595054757.jpg)